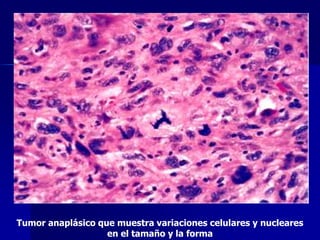
Tumor anaplásico que muestra variaciones celulares y nucleares
en el tamaño y la forma

Las neoplasias son proliferaciones anormales e incontroladas de tejido. Se clasifican en tumores benignos y malignos dependiendo de su capacidad de invasión y metástasis. El cáncer de cuello uterino comienza con lesiones premalignas llamadas displasias que pueden progresar a carcinoma in situ. Estas lesiones se originan en la zona de transformación del cuello uterino y su desarrollo está asociado a infecciones por virus del papiloma humano.